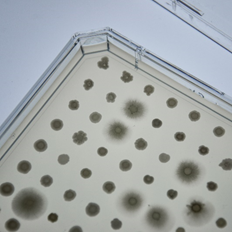
#ERAnet <a href="/ERA_CoBioTech/">ERA CoBioTech</a> <a href="/oleoferm/">Oleoferm ERA CoBioTech</a> WP3 is screening hundreds of wild yeasts to find the best for making microbial oils from short-chain fatty acids and modelling its metabolism.
#Biotechnology
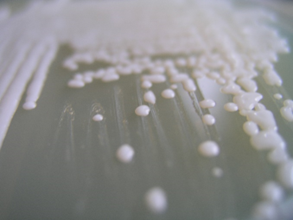
Some of the strains screened for conversion of short-chain fatty acids to microbial oils can grow at 25 g/L SCFAs. How cool is that?
#ERAnet <a href="/ERA_CoBioTech/">ERA CoBioTech</a> <a href="/oleoferm/">Oleoferm ERA CoBioTech</a> #Biotechnology

Oleoferm ERA CoBioTech
@oleoferm
Developing the production of microbial oils from organic waste. Project of ERA CoBioTech.
ID: 1439875748748267520
20-09-2021 08:55:28
48 Tweet
32 Followers
9 Following


#ERAnet ERA CoBioTech Oleoferm ERA CoBioTech WP2 takes care of anaerobic fermentation for SCFAs production, maximizing carbon recovery from organic waste used in production of short-chain fatty acids. #Biotechnology


We reached over 40% bioconversion yield in converting household food wastes to volatile fatty acids – producing a promising substrate for further conversion into valuable microbial oils! #ERAnet ERA CoBioTech Oleoferm ERA CoBioTech #Biotechnology


#ERAnet ERA CoBioTech Oleoferm ERA CoBioTech WP3 is screening hundreds of wild yeasts to find the best for making microbial oils from short-chain fatty acids and modelling its metabolism. #Biotechnology

We have a winner! The best yeast for conversion of short-chain fatty acids to microbial oils is now going through genome and transcriptome sequencing to explain its fantastic performance. #ERAnet ERA CoBioTech Oleoferm ERA CoBioTech #Biotechnology


#ERAnet ERA CoBioTech Oleoferm ERA CoBioTech WP4 is searching for optimal bioreactor conditions to produce and accumulate microbial oils during growth on short-chain fatty acids. #Biotechnology


Most important factors in production of microbial oils from short-chain fatty acids? C:N ration and the prevalence of shorter short-chain fatty acids. doi.org/10.1016/j.jece… #ERAnet ERA CoBioTech Oleoferm ERA CoBioTech #Biotechnology


#ERAnet ERA CoBioTech Oleoferm ERA CoBioTech WP5 is assessing cost, environmental impact, efficiency and social acceptability of organic waste conversion to microbial oils. #Biotechnology


We developed a simulation model for the production of microbial oils from organic waste, including waste pre-treatment, acidogenic fermentation, oleaginous fermentation, and extraction of lipids from oleaginous yeasts. #ERAnet ERA CoBioTech Oleoferm ERA CoBioTech #Biotechnology


#ERAnet ERA CoBioTech Oleoferm ERA CoBioTech WP6 is taking care of the dissemination of the results to the industrial and scientific community and to a broad stakeholder audience – science is great, communicating science is, too! #Biotechnology


Our mid-term workshop was attended by 57 registered participants from 24 different countries and 38 different institutions. Looking forward to helping our results reach an ever increasing audience. #ERAnet ERA CoBioTech Oleoferm ERA CoBioTech #Biotechnology


Acidogenic fermentation of organic waste to short-chain fatty acids at semi-industrial scale (250 L working volume!), performed at BIO-VALO. #ERAnet@ERA_CoBioTech Oleoferm ERA CoBioTech #Biotechnology


Some of the strains screened for conversion of short-chain fatty acids to microbial oils can grow at 25 g/L SCFAs. How cool is that? #ERAnet ERA CoBioTech Oleoferm ERA CoBioTech #Biotechnology

The final Oleoferm ERA CoBioTech conference attracted a large crowd! There were so many great results presented from both within the consortium and beyond. Thank you, IMDEA Energia for organising the event!


The final newsletter of the Oleoferm ERA CoBioTech project is now available online! online.fliphtml5.com/pewig/unxw/ IMDEA Energia ERA CoBioTech

After screening of 1434 yeast strains for their ability to produce high concentrations of microbial oils from SCFAs we now have a winner! Jožef Stefan Institute UL, Biotehniška fakulteta IMDEA Energia #OLEOFERM ERA CoBioTech #Biotechnology #ERAnet


Our yeast strain is capable of utilizing acetic, propionic, butyric, valeric and caproic acids and accumulates high amounts of microbial oils. Jožef Stefan Institute UL, Biotehniška fakulteta IMDEA Energia #OLEOFERM ERA CoBioTech #Biotechnology #ERAnet


One more step towards industrial conversion of short-chain fatty acids to microbial oils – a successful scale-up to a 250 L bioreactor has been achieved at BIO-VALO bio-valo.com IMDEA Energia#OLEOFERM ERA CoBioTech #Biotechnology #ERAnet


The life cycle sustainability assessment (LCSA) of a microbial oil system is now complete IMDEA Energia#OLEOFERM ERA CoBioTech #Biotechnology #ERAnet


The screening of 1434 yeast strains for the conversion of SCFAs to microbial oils has just been published: doi.org/10.1038/s41598… Jožef Stefan Institute UL, Biotehniška fakulteta IMDEA Energia #OLEOFERM ERA CoBioTech #Biotechnology #ERAnet #ic_mycosmo #culturecollection_ex

